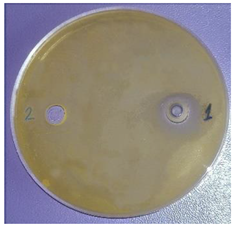
Plants 11 00896 i001
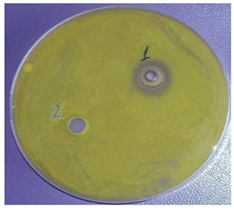
Plants 11 00896 i003

Chemical Composition and Antimicrobial Activity of Essential Oil of Fruits from Vitex agnus-castus L., Growing in Two Regions in Bulgaria
Abstract
:1. Introduction
2. Results
2.1. Chemical Composition of the Fruits
2.2. Chemical Composition of the Essential Oils (EOs)
2.3. Antimicrobial Activity of the Essential Oils (EOs)
2.4. Biologically Active Components in the Vegetable Oil from Vitex Fruits
3. Discussion
4. Materials and Methods
4.1. Plant Collection
4.2. Chemical Composition of the Fruits
4.3. Isolation of the Essential Оil (ЕО)
4.4. Chemical Composition of Essential Oil (EO)
4.5. Antimicrobial Activity of Essential Oil (EO)
4.6. Isolation of Vegetable Oil
4.6.1. Fatty Acid Composition
4.6.2. Determination of Sterols
4.6.3. Determination of Tocopherols
4.6.4. Determination of Phospholipids
4.7. Statistics
5. Conclusions
Author Contributions
Funding
Institutional Review Board Statement
Informed Consent Statement
Data Availability Statement
Acknowledgments
Conflicts of Interest
References
- Hammid, A.A.; Usman, L.A.; Adebayo, S.A.; Zubair, M.F.; Elaigwu, S.E. Chemical constituents of leaf essential oil of North-central Nigerian grown Vitex agnus-castus. Adv. Environ. Biol. 2010, 4, 250–253. [Google Scholar]
- Niroumand, M.; Heydarpour, F.; Farzaei, M. Pharmacological and therapeutic effects of Vitex agnus castus L.: A Review. Pharmacogn. Rev. 2018, 12, 103–114. [Google Scholar] [CrossRef]
- Eryigit, T.; Çig, A.; Okut, N.; Yildirim, B.; Ekici, K. Evaluation of chemical composition and antimicrobial activity of Vitex agnus castus L. fruits’ essential oils from West Anatolia, Turkey. J. Essent. Oil Bear Plants 2015, 18, 208–214. [Google Scholar] [CrossRef]
- El Kamari, F.; Taroq, A.; El Atki, Y.; Aouam, I.; Lyoussi, B.; Abdellaoui, A. Chemical composition of essential oils from Vitex agnus-castus L. growing in Morocco and its in vitro antibacterial activity against clinical bacteria responsible for nosocomial infections. Asian J. Pharm. Clin. Res. 2018, 11, 365–368. [Google Scholar] [CrossRef]
- Habbab, A.; Sekkouma, K.; Belboukharia, N.; Cheritib, A.; Aboul-Enein, H. Essential oil chemical composition of Vitex agnus-castus L. from Southern-West Algeria and its antimicrobial activity. Curr. Bioact. Compd. 2016, 12, 51–60. [Google Scholar] [CrossRef]
- Zhelev, I.; Batsalova, T.; Georgieva, L.; Dzhambazov, B.; Stoyanova, A.; Dimitrova-Duylgerova, I. Chemical composition, cytotoxity and antioxidant activity of essential oil from Vitex agnus-castus fruits, growing in Bulgaria. Oxid Commun. 2016, 39, 145–155. [Google Scholar]
- Haghighi, T.M.; Saharkhiz, M.J.; Khosravi, A.R.; Fard, F.R.; Moein, M. Essential oil content and composition of Vitex pseudo-negundo in Iran varies with ecotype and plant organ. Ind. Crops Prod. 2017, 109, 53–59. [Google Scholar] [CrossRef]
- Ghannadi, A.; Bagherinejad, M.R.; Abedi, D.; Jalali, M.; Absalan, B.; Sadeghi, N. Antibacterial activity and composition of essential oils from Pelargonium graveolens L’Her and Vitex agnus-castus L. Iran. J. Microbiol. 2012, 4, 171–176. [Google Scholar]
- Khalilzadeh, E.; Vafaei Saiah, G.; Hasannejad, H.; Ghaderi, A.; Ghaderi, S.; Hamidian, G.; Mahmoudi, R.; Eshgi, D.; Mahsa Zangisheh, M. Antinociceptive effects, acute toxicity and chemical composition of Vitex agnus-castus essential oil. Avicenna J. Phytomed. 2015, 5, 218–230. [Google Scholar]
- Ibrahim, N.; Shalaby, A.; Farag, R.; Elbaroty, G.; Hassa, E. Chemical composition and biological evaluation of Vitex agnus-castus L. Med. Aromat. Plant. Sci. Biotechnol. 2009, 3, 27–31. [Google Scholar]
- Ozkaya, A.; Ciftci, H.; Yilmaz, O.; Tel, A.; Cil, E.; Sitki Cevrimli, B. Vitamin, trace element, and fatty acid levels of Vitex agnus-castus L., Juniperus oxycedrus L., and Papaver somniferum L. plant seeds. J. Chem. 2013, 4, 845743. [Google Scholar] [CrossRef] [Green Version]
- Asdadi, A.; Idrissi Hassani, L.M.; Chebli, B.; Moutaj, R.; Gharby, S.; Harhar, H.; Salghi, R.; EL Hadek, M. Chemical composition and antifungal activity of Vitex agnus-castus L. seeds oil growing in Morocco. J. Mater. Environ. Sci. 2014, 5, 823–830. [Google Scholar]
- Food and Agriculture Organization of the United Nations. Food Energy—Methods of Analysis and Conversion Factors; FAO Food and Nutrition Paper, Report of a Technical Workshop; FAO: Rome, Italy, 2003; Volume 77. [Google Scholar]
- Montiel-Herrera, M.; Camacho-Hernandez, I.L.; Rios-Morgan, A.; DelgadoVargas, F. Partial physicochemical and nutritional characterization of the fruit of Vitex mollis (Verbenaceae). J. Food Comp. Anal. 2004, 17, 205–215. [Google Scholar] [CrossRef]
- Sorensen, J.M.; Katsiotis, S.T. Variation in essential oil yield and composition of Cretan Vitex agnus castus L. fruits. J. Essent. Oil Res. 1999, 11, 599–605. [Google Scholar] [CrossRef]
- Senatore, F.; Napolitano, F.; Ozcan, M. Chemical composition and antibacterial activity of essential oil from fruits of Vitex agnus-castus L. (Verbenaceae) growing in Turkey. J. Essent. Oil Bear Plant 2003, 6, 185–190. [Google Scholar] [CrossRef]
- Novak, J.; Draxler, L.; Göhler, I.; Franz, C. Essential oil composition of Vitex agnus-castus—Comparison of accessions and different plant organs. Flavour Fragr. J. 2005, 20, 186–192. [Google Scholar] [CrossRef]
- Taziki, S.; Hamedeyazdan, S.; Pasandi, A. Variations in essential oils of Vitex agnus castus fruits growing in Qum, Khorasan and Tehran in Iran. Ann. Biol. Res. 2013, 4, 308–312. [Google Scholar]
- Ulukanli, Z.; Çenet, M.; Öztürk, B.; Bozok, F.; Karabörklü, S.; Cercis Demirci, S. Chemical characterization, phytotoxic, antimicrobial and insecticidal activities of Vitex agnus-castus’ essential oil from East Mediterranean region. J. Essent. Oil Bear Plant 2015, 18, 1500–1507. [Google Scholar] [CrossRef]
- Ekundayo, O.; Laakso, I.; Holopainen, M.; Hiltunen, R.; Oguntimein, B.; Kauppinen, V. The chemical composition and antimicrobial activity of the leaf oil of Vitex agnus-castus L. J. Essent. Oil Res. 1990, 2, 115–119. [Google Scholar] [CrossRef]
- Georgiev, E.; Stoyanova, A. A Guide for the Specialist in the Aromatic Industry Cultivation; University of Food Technologies Publ. House: Plovdiv, Bulgaria, 2005. [Google Scholar]
- Başer, K.; Buchbauer, G. Handbook of Essential Oils: Science, Technology, and Applications, 1st ed.; Taylor and Francis Group, LLC.: Abingdon, UK; CRC Press: Boca Raton, FL, USA, 2010. [Google Scholar]
- Rota, M.C.; Herrera, A.; Martinez, R.M.; Sotomayor, J.A.; Jordan, M.J. Antimicrobial activity and chemical composition of Thymus vulgaris, Thymus zygis and Thymus hyemalis essential oils. Food Control 2008, 19, 681–687. [Google Scholar] [CrossRef]
- Gabrıellı, G.; Loggını, F.; Cıonı, P.; Gıannaccını, B.; Mancuso, E. Activity of lavandino essential oil against non-tubercular opportunistic rapid grown Mycobacteria Pharm. Res. Commun. 1988, 20, 37–40. [Google Scholar] [CrossRef]
- Fontanel, D. Unsaponifiable Matter in Plant Seed Oils; Springer: London, UK, 2013. [Google Scholar]
- Codex Alimentarius Commission. Codex-Stan 210: Codex Standard for Named Vegetable Oils; FAO: Rome, Italy, 2008. [Google Scholar]
- Asdadi, A.; Hamdouch, A.; Gharby, S.; Moutaj, R.; Hadek, M.; Chebli, B.; Hassani, L.M.I. In vitro synergistic effect of essential and fatty oils of Vitex agnus-castus L. and their combinations with Amphotericin B and Fluconazole against clinical isolates of nosocomial Candida Species. J. Colloid Sci. Biotechnol. 2015, 4, 170–178. [Google Scholar] [CrossRef]
- Mišurcová, L.; Vávra Ambrožová, J.; Samek, D. Seaweed lipids as nutraceuticals. Adv. Food Nutr. Res. 2011, 64, 339–355. [Google Scholar] [CrossRef] [PubMed]
- Konuskan, D.B.; Arslan, M.; Oksuz, A. Physicochemical properties of cold pressed sunflower, peanut, rapeseed, mustard and olive oils grown in the Eastern Mediterranean region. Saudi J. Biol. Sci. 2019, 26, 340–344. [Google Scholar] [CrossRef] [PubMed]
- Gharby, S.; Harhar, H.; Monfalouti, H.; Kartah, B.; Maata, N.; Guillaume, D.; Charrouf, Z. Chemical and oxidative properties of olive and argan oils sold on the Moroccan market. A comparative study. Med. J. Nutr. Metab. 2012, 5, 31–38. [Google Scholar] [CrossRef]
- Tapiero, H.; Townsend, D.M.; Tew, K.D. Phytosterols in the prevention of human pathologies. Biomed. Pharmacother. 2003, 57, 321–325. [Google Scholar] [CrossRef]
- Tlili, N.; Trabelsi, H.; Renaud, J.; Khaldi, A.; Mayer, P.M.; Saida, T. Triacylglycerols and phospholipids composition of caper seeds (Capparis spinosa). J. Am. Oil Chem. Soc. 2011, 88, 1787–1793. [Google Scholar] [CrossRef]
- Küllenberg, D.; Taylor, L.A.; Schneider, M.; Massing, U. Health effects of dietary phospholipids. Lipids Health Dis 2012, 11, 3. [Google Scholar] [CrossRef] [PubMed] [Green Version]
- AOAC—Association of Official Analytical Chemist. Official Methods of Analysis, 20th ed.; AOAC: Arlington, VA, USA, 2016; Method 976.06. [Google Scholar]
- Bulgarian State Standard 13488:1976; Grain. Method for Determining the Starch Content. BSS: Sofia, Bulgaria, 1976.
- Bulgarian State Standard 7169:1989; Products of Processed Fruit and Vegetables. Determination of Sugar Content. BSS: Sofia, Bulgaria, 1989.
- Balinova, A.; Diakov, G. On improved apparatus for microdistillation of rose flowers. Plant Sci. 1974, 11, 77–85. [Google Scholar]
- Balouiri, M.; Sadiki, M.; Koraichi Ibnsouda, S. Methods for in vitro evaluating antimicrobial activity: A review. J. Pharm. Anal. 2016, 6, 71–79. [Google Scholar] [CrossRef] [Green Version]
- ISO 659:2014; Oilseeds. Determination of Oil Content (Reference Method). ISO: Geneva, Switzerland, 2014.
- ISO 12966-1:2014; Animal and Vegetable Fats and Oils. Gas Chromatography of Fatty Acid Methyl Esters—Part 1: Guidelines on Modern Gas Chromatography of Fatty Acid Methyl Esters. ISO: Geneva, Switzerland, 2014.
- ISO 12966-2:2017; Animal and Vegetable Fat and Oils. Gas Chromatography of Fatty Acid Methyl Esters—Part 2: Preparation of Methyl Esters of Fatty Acids. ISO: Geneva, Switzerland, 2017.
- ISO 18609:2000; Animal and Vegetable Fats and Oils. Determination of Unsaponifiable Matter. Method Using Hexane Extraction. ISO: Geneva, Switzerland, 2000.
- Ivanov, S.; Bitcheva, P.; Konova, B. Méthode de détermination chromatographyque et colorimétrique des phytosterols dans les huiles végétales et les concentres steroliques. Rev. Fr. Corps Gras 1972, 19, 177–180. [Google Scholar]
- ISO 12228-1:2014; Animal and Vegetable Fats and Oils. Determination of Individual and Total Sterols Contents. Gas Chromatographic Method. ISO: Geneva, Switzerland, 2014.
- ISO 9936:2016; Animal and Vegetable Fats and Oils. Determination of Tocopherol and Tocotrienol Contents by High-Performance Liquid Chromatography. ISO: Geneva, Switzerland, 2016.
- Folch, J.; Lees, M.; Sloane-Stanley, G.H. A simple method for the isolation and purification of total lipids from animal tissues. J. Biol. Chem. 1957, 226, 497–509. [Google Scholar] [CrossRef]
- Schneiter, R.; Daum, G. Analysis of yeast lipids. In Methods in Molecular Biology, 2nd ed.; Xiao, W., Ed.; Humana Press Inc.: Totowa, NJ, USA, 2006; pp. 75–84. [Google Scholar]
- ISO 10540-1:2014; Animal and Vegetable Fats and Oils. Determination of Phosphorus Content. Part 1: Colorimetric Method. ISO: Geneva, Switzerland, 2014.

| Content, % | Sample 1 (South-Central Bulgaria) | Sample 2 (North-East Bulgaria) |
|---|---|---|
| Moisture | 10.7 ± 0.2 a,2 | 9.6 ± 0.1 b |
| Proteins | 7.4 ± 0.1 a | 5.3 ± 0.1 b |
| Carbohydrates | 73.9 ± 0.7 a | 78.8 ± 0.8 b |
| starch | 23.8 ± 0.2 a | 14.1 ± 0.1 b |
| available sugars | 1.0 ± 0.1 a | 0.7 ± 0.0 b |
| fiber | 47.2 ± 0.5 a | 49.9 ± 0.5 b |
| Ash | 3.0 ± 0.2 a | 2.5 ± 0.1 b |
| Essential oil | 0.5 ± 0.1 a | 0.5 ± 0.0 a |
| Vegetable oil | 5.0 ± 0.1 a | 3.8 ± 0.2 b |
| No. | Compounds, % | RI | Sample 1 (South-Central Bulgaria) | Sample 2 (North-East Bulgaria) |
|---|---|---|---|---|
| 1. | α-Thujene | 931 | 0.2 ± 0.0 | - 2 |
| 2. | α-Pinene | 939 | 16.6 ± 0.15 b,3 | 7.2 ± 0.1 a |
| 3. | Camphene | 954 | 0.3 ± 0.0 | - |
| 4. | Sabinene | 971 | 14.5 ± 0.1 b | 6.7 ± 0.1 a |
| 5. | β-Pinene | 979 | 1.5 ± 0.0 b | 1.2 ± 0.0 a |
| 6. | β-Myrcene | 991 | 2.6 ± 0.0 b | 2.1 ± 0.0 a |
| 7. | α-Phellandrene | 1003 | 1.9 ± 0.0 b | 0.9 ± 0.0 a |
| 8. | α-Terpinene | 1014 | 0.3 ± 0.0 b | 0.6 ± 0.0 a |
| 9. | p-Cymene | 1022 | - | 1.2 ± 0.0 |
| 10. | Limonene | 1029 | 5.3 ± 0.1 | - |
| 11. | 1,8-Cineole | 1032 | 18.8 ± 0.2 b | 16.9 ± 0.2 a |
| 12. | γ-Terpinene | 1055 | 1.4 ± 0.0 b | 1.2 ± 0.0 a |
| 13. | cis-Sabinene hydrate | 1065 | 0.2 ± 0.0 | - |
| 14. | Terpinolene | 1080 | - | 0.5 ± 0.0 |
| 15. | β-Linalool | 1096 | 0.5 ± 0.0 a | 0.5 ± 0.0 a |
| 16. | cis-p-Menth-2-en-1-ol | 1118 | - | 0.2 ± 0.0 |
| 17. | trans-p-Menth-2-en-1-ol | 1136 | - | 0.2 ± 0.0 |
| 18. | Terpinen-4-ol | 1179 | 1.2 ± 0.0 b | 4.0 ± 0.0 a |
| 19. | α-Terpineol | 1189 | 2.0 ± 0.0 b | 3.9 ± 0.0 a |
| 20. | β-Citronellol | 1208 | - | 0.3 ± 0.0 |
| 21. | Nerol | 1227 | - | 0.2 ± 0.0 |
| 22. | Geraniol | 1249 | - | 0.2 ± 0.0 |
| 23. | δ-Terpinyl acetate | 1316 | - | 0.3 ± 0.0 |
| 24. | α-Terpinyl acetate | 1333 | 3.3 ± 0.0 b | 6.0 ± 0.1 a |
| 25. | β-Elemene | 1390 | 0.5 ± 0.0 | - |
| 26. | α-Gurjunene | 1409 | - | 3.4 ± 0.0 |
| 27. | β-Caryophyllene | 1429 | 6.6 ± 0.1 b | 9.0 ± 0.1 a |
| 28. | (Z)-Farnesene | 1442 | - | 1.0 ± 0.0 |
| 29. | β-(E)-Farnesene | 1454 | - | 8.0 ± 0.1 |
| 30. | α-Caryophyllene | 1456 | - | 0.6 ± 0.0 |
| 31. | Alloaromadendrene | 1461 | - | 4.4 ± 0.0 |
| 32. | Germacrene D | 1484 | 0.6 ± 0.0 | - |
| 33. | Elixene | 1492 | - | 1.11 ± 0.0 |
| 34. | Bicyclogermacrene | 1501 | 9.0 ± 0.1 b | 7.3 ± 0.1 a |
| 35. | γ-Cadinene | 1513 | - | 0.4 ± 0.0 |
| 36. | δ-Cadinene | 1522 | - | 0.5 ± 0.0 |
| 37. | Caryophyllene oxide | 1574 | 0.5 ± 0.0 b | 1.4 ± 0.0 a |
| 38. | Globulol | 1590 | - | 0.3 ± 0.0 |
| 39. | Ledol | 1602 | 2.0 ± 0.0 b | 1.1 ± 0.0 a |
| 40. | (-)-Spathulenol | 1619 | 0.5 ± 0.0 b | 2.4 ± 0.0 a |
| 41. | tau-Cadinol | 1628 | 3.4 ± 0.0 b | 2.2 ± 0.0 a |
| 42. | α-Cadinol | 1641 | - | 1.7 ± 0.0 |
| 43. | β-Eudesmol | 1642 | 0.1 ± 0.0 | - |
| 44. | n-Heptadecane | 1700 | 0.2 ± 0.0 | - |
| 45. | n-Heneicosane | 2100 | 0.2 ± 0.0 | - |
| 46. | Phytol | 2105 | 0.3 ± 0.0 | - |
| 47. | n-Docosane | 2200 | 0.4 ± 0.0 | - |
| 48. | n-Tricosane | 2300 | 0.4 ± 0.0 | - |
| 49. | n-Tetracosane | 2400 | 0.2 ± 0.0 | - |
| 50. | n-Pentacosane | 2500 | 0.2 ± 0.0 | - |
| 51. | n-Hexacosane | 2600 | 0.4 ± 0.0 | - |
| 52. | n-Heptacosane | 2700 | 0.7 ± 0.0 | - |
| 53. | Octacosane | 2800 | 0.6 ± 0.0 | - |
| 54. | Squalene | 2817 | 0.7 ± 0.0 | - |
| Aliphatic hydrocarbons, % | 3.5 | - | ||
| Monoterpene hydrocarbons, % | 45.5 | 20.5 | ||
| Oxygenated monoterpene, % | 26.5 | 32.7 | ||
| Sesquiterpene hydrocarbons, % | 17.0 | 36.5 | ||
| Oxygenated sesquiterpenes, % | 6.5 | 9.1 | ||
| Diterpenes, % | 0.3 | - | ||
| Triterpenes, % | 0.7 | - | ||
| Phenyl propanoids, % | - | 1.2 | ||
| Tested Microorganisms | Inhibition Zone (mm) 3,4 | |
|---|---|---|
| Staphylococcus aureus ATCC 6538 | 11.25 ± 0.05 | ![]() |
| Bacillus subtilis ATCC 6633 | 12.03 ± 0.02 | ![]() |
| Kocuria rhizophila ATCC 9341 | 9.37 ± 0.04 | ![]() |
| Escherichia coli ATCC 8739 | 8.00 ± 0.0 | ![]() |
| Pseudomonas aeruginosa ATCC 9027 | 8.03 ± 0.02 | ![]() |
| Salmonella abony NCTC 6017 | 11.15 ± 0.05 | ![]() |
| Saccharomyces cerevisiae ATCC 2601 | 11.86 ± 0.03 | |
| Biologically Active Components | Sample 1 (South-Central Bulgaria) | Sample 2 (North-East Bulgaria) |
|---|---|---|
| Unsaponifiable matter, % | ||
| in the oil | 16.6 ± 0.1 a,2 | 24.6 ± 0.2 b |
| in the fruits | 0.8 ± 0.0 a | 0.9 ± 0.0 b |
| Sterols, % | ||
| in the oil | 1.4 ± 0.1 a | 1.5 ± 0.2 a |
| in the fruits | 0.1 ±0.0 a | 0.1 ± 0.0 a |
| Phospholipids, % | ||
| in the oil | 10.4 ± 0.1 a | 9.3 ± 0.1 b |
| in the fruits | 0.5 ± 0.0 a | 0.4 ± 0.0 b |
| Tocopherols, mg/kg | ||
| in the oil | 164 ± 2 b | 305 ± 3 a |
| in the fruits | 8.1 ± 0.1 b | 11.6 ± 0.1 a |
| Fatty Acids, % | Sample 1 (South-Central Bulgaria) | Sample 2 (North-East Bulgaria) | |
|---|---|---|---|
| Caprylic | C 8:0 | - 2 | 0.1 ± 0.0 |
| Capric | C 10:0 | 0.8 ± 0.2 a,4 | 0.3 ± 0.1 b |
| Lauric | C 12:0 | 0.3 ± 0.0 a | 0.1 ± 0.0 b |
| Myristic | C 14:0 | 0.5 ± 0.1 a | 0.2 ± 0.0 b |
| Palmitic | C 16:0 | 9.0 ± 0.2 a | 8.9 ± 0.1 a |
| Palmitoleic | C 16:1 | 0.3 ± 0.0 a | 1.5 ± 0.1 b |
| Margaric | C 17:0 | 0.2 ± 0.0 a | 0.4 ± 0.0 b |
| Stearic | C 18:0 | 3.4 ± 0.2 a | 4.2 ± 0.3 b |
| Oleic | C 18:1 | 14.0 ± 0.1 a | 16.1 ± 0.1 b |
| Linoleic | C 18:2 | 71.5 ± 0.7 a | 66.1 ± 0.6 b |
| Linolenic | C 18:3 | - | 0.6 ± 0.0 |
| Arachidic | C 20:0 | - | 1.5 ± 0.1 |
| SFA 3 | 14.2 | 15.7 | |
| UFA | 85.8 | 84.3 | |
| MUFA | 14.3 | 17.6 | |
| UFA | 71.5 | 66.7 | |
| Compounds, % | Sample 1 (South-Central Bulgaria) | Sample 2 (North-East Bulgaria) |
|---|---|---|
| Sterols | ||
| Brassicasterol | 12.3 ± 0.1 a,3 | 12.0 ± 0.1 b |
| Campesterol | 13.3 ± 0.1 a | 21.7 ± 0.2 b |
| Stigmasterol | 7.1 ± 0.2 a | 3.1± 0.1 b |
| β-Sitosterol | 43.3 ±0.4 a | 57.1± 0.6 b |
| Δ5-Avenasterol | 24.0 ± 0.2 a | 6.1± 0.1 b |
| Tocopherols | ||
| α-Tocopherol | 21.3 ± 0.2 | - 2 |
| γ-Tocopherol | 78.7 ± 0.8 a | 100 ± 0.0 b |
| Phospholipids | ||
| Phosphatidylinositol | 18.3 ± 0.2 a | 14.1 ± 0.1 b |
| Phosphatidylcholine | 14.3 ± 0.1 a | 12.6 ± 0.1 b |
| Phosphatidylethanolamine | 17.1 ± 0.2 a | 16.7 ± 0.2 a |
| Phosphatidic acids | 16.8 ± 0.2 a | 23.7 ± 0.3 b |
| Phosphatidylserine | 11.1 ± 0.1 a | 10.7 ± 0.1 b |
| Lysophosphatidylethanolamine | 11.0 ± 0.2 a | 11.2 ± 0.1 a |
| Lysophosphatidylcholine | 11.4 ± 0.1 a | 11.0 ± 0.2 b |
Publisher’s Note: MDPI stays neutral with regard to jurisdictional claims in published maps and institutional affiliations. |
© 2022 by the authors. Licensee MDPI, Basel, Switzerland. This article is an open access article distributed under the terms and conditions of the Creative Commons Attribution (CC BY) license (https://creativecommons.org/licenses/by/4.0/).
Share and Cite
Zhelev, I.; Petkova, Z.; Kostova, I.; Damyanova, S.; Stoyanova, A.; Dimitrova-Dyulgerova, I.; Antova, G.; Ercisli, S.; Assouguem, A.; Kara, M.; et al. Chemical Composition and Antimicrobial Activity of Essential Oil of Fruits from Vitex agnus-castus L., Growing in Two Regions in Bulgaria. Plants 2022, 11, 896. https://doi.org/10.3390/plants11070896
Zhelev I, Petkova Z, Kostova I, Damyanova S, Stoyanova A, Dimitrova-Dyulgerova I, Antova G, Ercisli S, Assouguem A, Kara M, et al. Chemical Composition and Antimicrobial Activity of Essential Oil of Fruits from Vitex agnus-castus L., Growing in Two Regions in Bulgaria. Plants. 2022; 11(7):896. https://doi.org/10.3390/plants11070896
Chicago/Turabian StyleZhelev, Iliya, Zhana Petkova, Iliana Kostova, Stanka Damyanova, Albena Stoyanova, Ivanka Dimitrova-Dyulgerova, Ginka Antova, Sezai Ercisli, Amine Assouguem, Mohammed Kara, and et al. 2022. "Chemical Composition and Antimicrobial Activity of Essential Oil of Fruits from Vitex agnus-castus L., Growing in Two Regions in Bulgaria" Plants 11, no. 7: 896. https://doi.org/10.3390/plants11070896
APA StyleZhelev, I., Petkova, Z., Kostova, I., Damyanova, S., Stoyanova, A., Dimitrova-Dyulgerova, I., Antova, G., Ercisli, S., Assouguem, A., Kara, M., Almeer, R., & Sayed, A. A. (2022). Chemical Composition and Antimicrobial Activity of Essential Oil of Fruits from Vitex agnus-castus L., Growing in Two Regions in Bulgaria. Plants, 11(7), 896. https://doi.org/10.3390/plants11070896